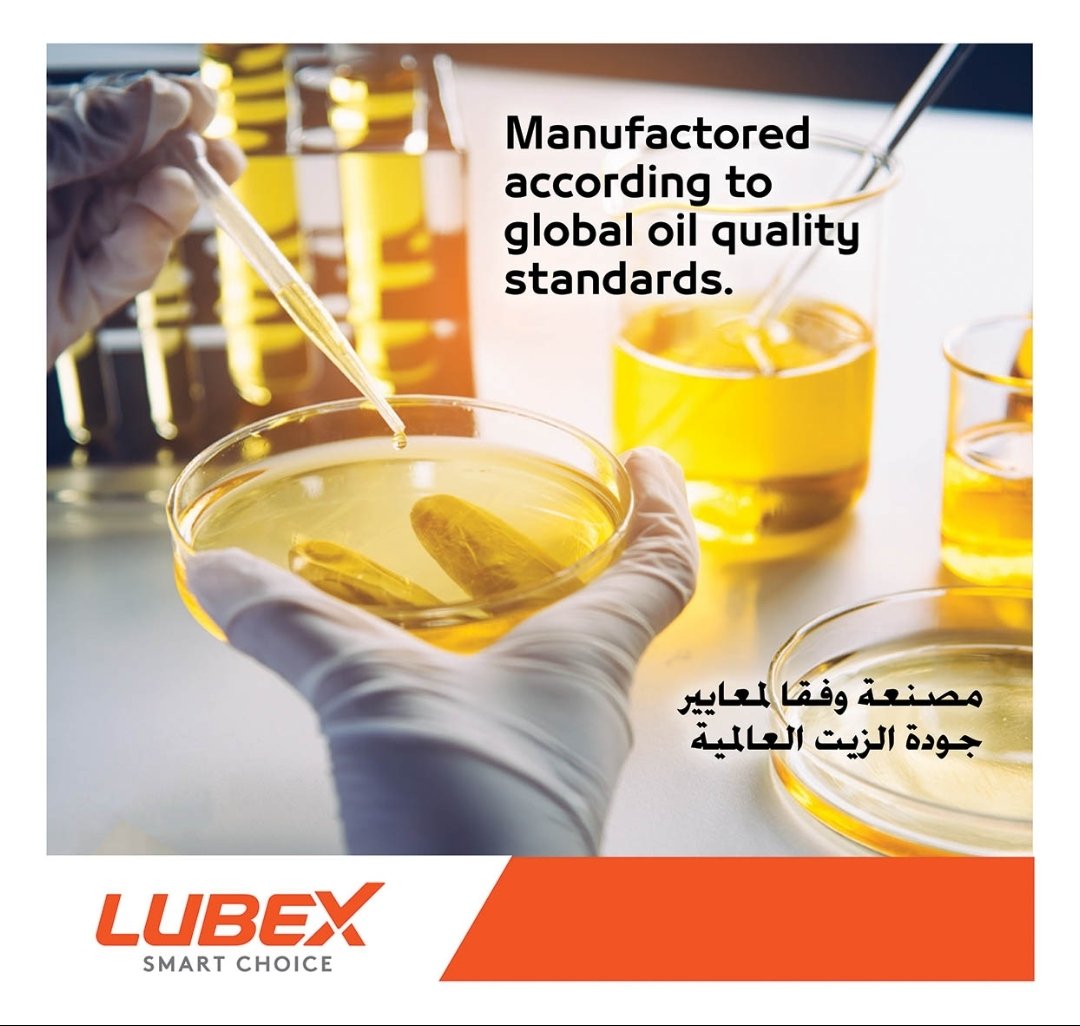
زيوت لوبكس

الاقسام
- سائل التبريد الراديتر
- زيوت الهيدروليك ناقل الحركة الجير الاوتوماتيك
- الطاوات
- FILTON FILTERS Oils
- FILTON FILTERS
- FILTON FILTERS AIR
- FILTON FILTERS Air.
- منتجات العناية بنظام الوقود - Fuel System Care Products
- منتجات تحسين أداء الديزل - Diesel Performance Products
- منتجات العناية وحماية المحرك - Engine Care & Protection Products
- إطارات
- زيوت جملة
- زيوت الفرامل
- فلاتر الزيت
- قطع الغيار
- زيوت السيارات
- فلاتر الهواء
- التبريد والتكييف
- زيوت الدفرنش
- منتجات العناية بالسيارة
- زيوت الجير العادي
-
-
أهلاً بك